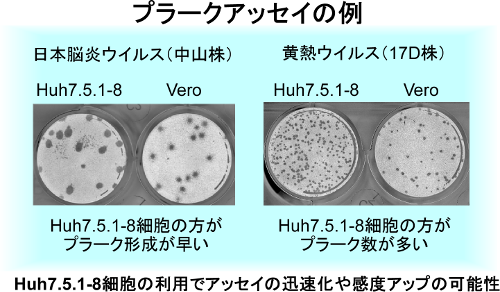

Comparative characterization of flavivirus production in two cell lines: Human hepatoma-derived Huh7.5.1-8 and African green monkey kidney-derived Vero.
Kyoko Saito, Masayoshi Fukasawa, Yoshitaka Shirasago, Ryosuke Suzuki, Naoki Osada, Toshiyuki Yamaji, Takaji Wakita, Eiji Konishi, Kentaro Hanada
未知のウイルスを分離したり、増やしたりする上で、培養細胞は欠かせない存在です。様々なウイルスの増殖性が高く、研究・ウイルスワクチン生産に汎用されている細胞として、アフリカミドリザル腎由来Vero細胞が知られています。一方、私たちはこれまでに、C型肝炎ウイルスの増殖性が高い、ヒト肝がん由来Huh7.5.1-8細胞を樹立しました(Shirasago et al. Jpn J Infect Dis. 68(2):81, 2015)。
今回、Huh7.5.1-8細胞とVero細胞との間で、 “フラビウイルス”に属する日本脳炎ウイルスと黄熱ウイルス(ワクチン株)の産生能を比較しました。その結果、(1)Huh7.5.1-8細胞は感染初期にVero細胞よりもウイルス生産量が高いこと、(2)Huh7.5.1-8細胞は Vero細胞よりもウイルス感染によって死にやすいこと、がわかりました。ウイルスの定量にはプラークアッセイという方法が使われますが、Huh7.5.1-8細胞を用いて同アッセイを行うと、Vero細胞を用いるよりも早くプラークを形成する(日本脳炎ウイルスの場合)、あるいはより多くのプラークを形成する(黄熱ウイルスの場合)ことが観察されました。これらの結果は、Huh7.5.1-8細胞がフラビウイルス分離や検査に有用であることを示しています(感染研・北大・阪大微研の共同研究)。